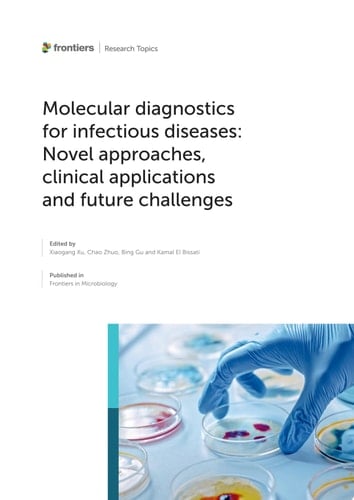
Molecular diagnostics for infectious diseases: Novel approaches, clinical applications and future challenges

Molecular diagnostics for infectious diseases: Novel approaches, clinical applications and future challenges
0
0
Author Description
Page Count:
193
Publication Date:
2023-03-31
ISBN-10:
2832519490
ISBN-13:
9782832519493
Community Tags
Reader Comments
Share Your Thoughts
No comments yet. Be the first to share your thoughts!